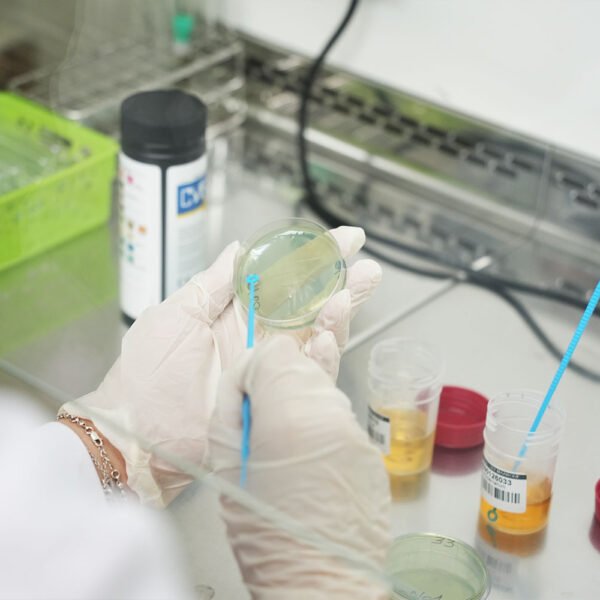

Découvrez en images l’univers du Laboratoire Sidi Maarouf :
Un espace moderne, sécurisé et pensé pour le confort des patients. Cette galerie reflète notre environnement de travail, la qualité de nos installations et l’attention portée à chaque détail pour garantir une prise en charge fiable et sereine.